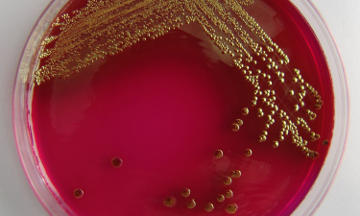
Análisis bacteriológicos

Versatilidad
Nuestro laboratorio tiene el equipamiento y los recursos humanos para realizar análisis para un amplio espectro de industrias
Personalización
Atendemos a cada cliente en forma personalizada, resolviendo sus inquietudes acerca de nuestros servicios, entregando reportes completos
Calidad
Contamos con un completo sistema de calidad, que nos permite cumplir con la normativa vigentes para la realización de análisis de distintos tipos
¿Tiene preguntas sobre nuestros servicios? ¿Necesita un desarrollo personalizado?
Contáctenos , nuestro personal resolverá sus dudas.
Realizamos análisis químicos para múltiples industrias y consultoría ambiental
Contamos con certificación de Cofilab y OPDS

Nuestros servicios incluyen:
Análisis por cromatografía líquida, gaseosa y espectrofotometría
Análisis bacteriológicos
Consultoría ambiental
Plataforma digital para clientes
Acceso en tiempo real a los datos de sus análisis desde el panel de clientes
Reportes individualizados para las muestras
Validaciones de técnicas analíticas
Desarrollo de métodos de análisis
Toma de muestra ambiental y para higiene y seguridad